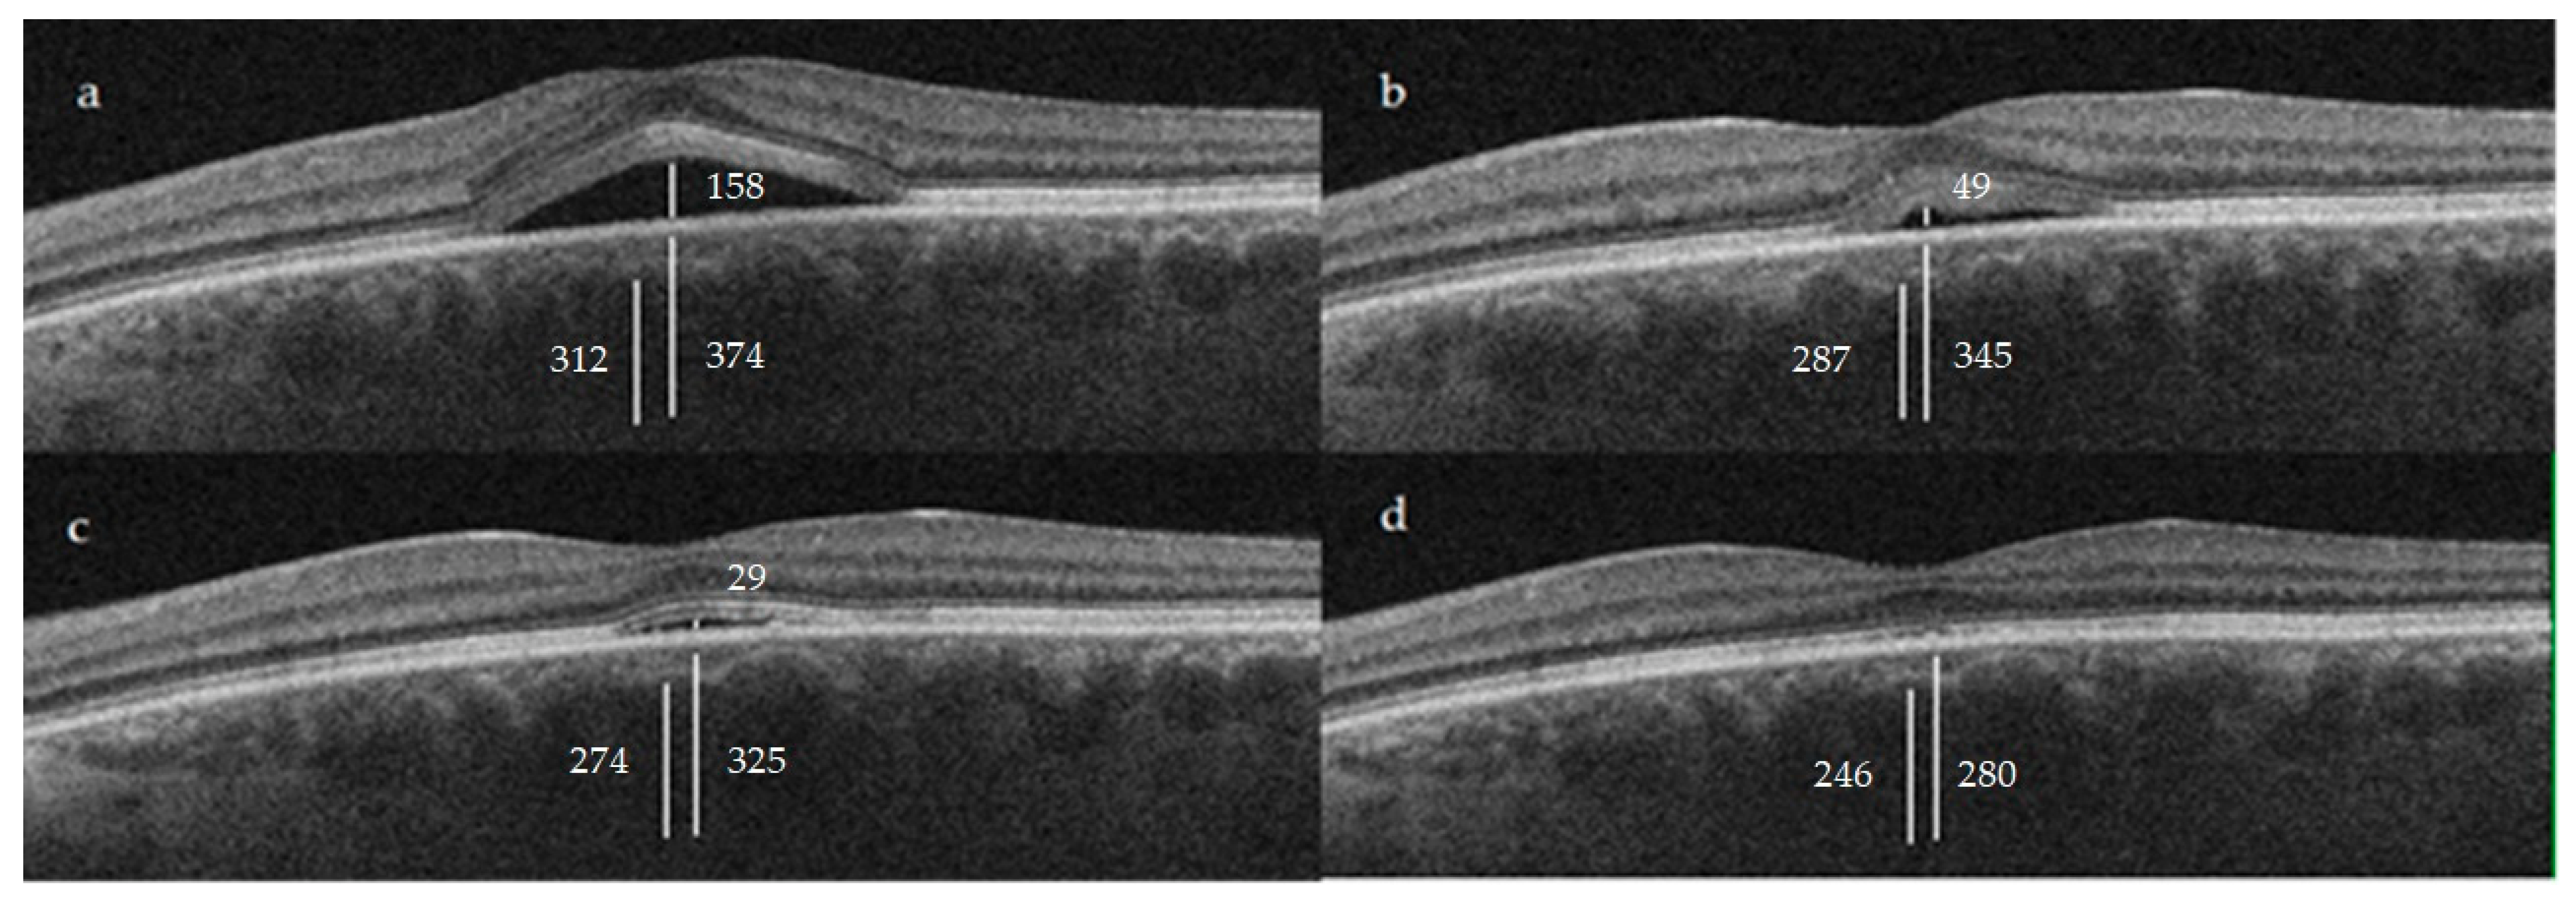
Jcm 12 01127 g002 Jcm 12 01127 g002

Effectiveness, Safety and Choroidal Changes of a Fovea-Sparing Technique for the Treatment of Chronic Central Serous Chorioretinopathy with Yellow Subthreshold Laser
Abstract
1. Introduction
2. Materials and Methods
2.1. Study Design
2.2. Patients
2.3. Procedures
2.4. Outcomes
2.5. Control Group
2.6. Statistical Analysis
3. Results
3.1. Subretinal Fluid (SRF)
3.2. Best-Corrected Visual Acuity (BCVA)
3.3. Choroidal Thickness (CT)
3.4. Adverse Events
4. Discussion
5. Conclusions
Author Contributions
Funding
Institutional Review Board Statement
Informed Consent Statement
Data Availability Statement
Conflicts of Interest
References
- Wang, M.; Munch, I.C.; Hasler, P.W.; Prünte, C.; Larsen, M. Central serous chorioretinopathy. Acta Ophthalmol. 2008, 86, 126–145. [Google Scholar] [CrossRef] [PubMed]
- Daruich, A.; Matet, A.; Dirani, A.; Bousquet, E.; Zhao, M.; Farman, N.; Jaisser, F.; Behar-Cohen, F. Central serous chorioretinopathy: Recent findings and new physiopathology hypothesis. Prog. Retin. Eye Res. 2015, 48, 82–118. [Google Scholar] [CrossRef] [PubMed]
- Semeraro, F.; Morescalchi, F.; Russo, A.; Gambicorti, E.; Pilotto, A.; Parmeggiani, F.; Bartollino, S.; Costagliola, C. Central Serous Chorioretinopathy: Pathogenesis and Management. Clin. Ophthalmol. 2019, 13, 2341–2352. [Google Scholar] [CrossRef] [PubMed]
- Mrejen, S.; Spaide, R.F. Optical coherence tomography: Imaging of the choroid and beyond. Surv. Ophthalmol. 2013, 58, 387–429. [Google Scholar] [CrossRef] [PubMed]
- Cheung, C.; Lee, W.K.; Koizumi, H.; Dansingani, K.; Lai, T.; Freund, K.B. Pachychoroid disease. Eye 2019, 33, 14–33. [Google Scholar] [CrossRef]
- Scholz, P.; Altay, L.; Fauser, S. A Review of Subthreshold Micropulse Laser for Treatment of Macular Disorders. Adv. Ther. 2017, 34, 1528–1555. [Google Scholar] [CrossRef]
- Arsan, A.; Kanar, H.S.; Sonmez, A. Visual outcomes and anatomic changes after sub-threshold micropulse yellow laser (577-nm) treatment for chronic central serous chorioretinopathy: Long-term follow-up. Eye 2018, 32, 726–733. [Google Scholar] [CrossRef]
- Chhablani, J.; SOLS (Subthreshold Laser Ophthalmic Society) Writing Committee. Subthreshold laser therapy guidelines for retinal diseases. Eye 2022, 36, 2234–2235. [Google Scholar] [CrossRef]
- Branchini, L.A.; Adhi, M.; Regatieri, C.V.; Nandakumar, N.; Liu, J.J.; Laver, N.; Fujimoto, J.G.; Duker, J.S. Analysis of choroidal morphologic features and vasculature in healthy eyes using spectral-domain optical coherence tomography. Ophthalmology 2013, 120, 1901–1908. [Google Scholar] [CrossRef]
- Sun, Z.; Huang, Y.; Nie, C.; Wang, Z.; Pei, J.; Lin, B.; Zhou, R.; Zhang, J.; Chong, V.; Liu, X. Efficacy and safety of subthreshold micropulse laser compared with threshold conventional laser in central serous chorioretinopathy. Eye 2020, 34, 1592–1599. [Google Scholar] [CrossRef]
- Scholz, P.; Altay, L.; Fauser, S. Comparison of subthreshold micropulse laser (577 nm) treatment and half-dose photodynamic therapy in patients with chronic central serous chorioretinopathy. Eye 2016, 30, 1371–1377. [Google Scholar] [CrossRef]
- Flores-Moreno, I.; Arcos-Villegas, G.; Sastre, M.; Ruiz-Medrano, J.; Arias-Barquet, L.; Duker, J.S.; Ruiz-Moreno, J.M. Changes in choriocapillaris, Sattler, and Haller layer thickness in central serous chorioretinopathy after half-fluence photodynamic therapy. Retina 2020, 40, 2373–2378. [Google Scholar] [CrossRef]
- Schubert, C.; Pryds, A.; Zeng, S.; Xie, Y.; Freund, K.B.; Spaide, R.F.; Merriam, J.C.; Barbazetto, I.; Slakter, J.S.; Chang, S.; et al. Cadherin 5 is regulated by corticosteroids and associated with central serous chorioretinopathy. Hum. Mutat. 2014, 35, 859–867. [Google Scholar] [CrossRef]
- Zhao, M.; Célérier, I.; Bousquet, E.; Jeanny, J.C.; Jonet, L.; Savoldelli, M.; Offret, O.; Curan, A.; Farman, N.; Jaisser, F.; et al. Mineralocorticoid receptor is involved in rat and human ocular chorioretinopathy. J. Clin. Investig. 2012, 122, 2672–2679. [Google Scholar] [CrossRef]
- Kim, Y.H.; Lee, B.; Kang, E.; Oh, J. Peripapillary Choroidal Vascularity Outside the Macula in Patients with Central Serous Chorioretinopathy. Transl. Vis. Sci. Technol. 2021, 10, 9. [Google Scholar] [CrossRef]
- Agrawal, R.; Salman, M.; Tan, K.A.; Karampelas, M.; Sim, D.A.; Keane, P.A.; Pavesio, C. Choroidal Vascularity Index (CVI)-A Novel Optical Coherence Tomography Parameter for Monitoring Patients with Panuveitis? PLoS ONE 2016, 11, e0146344. [Google Scholar] [CrossRef]
- Sirks, M.J.; van Dijk, E.H.C.; Rosenberg, N.; Hollak, C.E.M.; Aslanis, S.; Cheung, C.M.G.; Chowers, I.; Eandi, C.M.; Freund, K.B.; Holz, F.G.; et al. Clinical impact of the worldwide shortage of verteporfin (Visudyne®) on ophthalmic care. Acta Ophthalmol. 2022, 100, e1522–e1532. [Google Scholar] [CrossRef]
- Shortage of Visudyne (Verteporfin), European Medicine Agency. Available online: https://www.ema.europa.eu/en/documents/shortage/visudyne-verteporfin-supply-shortage_en.pdf (accessed on 14 January 2023).
- Van Dijk, E.H.C.; Fauser, S.; Breukink, M.B.; Blanco-Garavito, R.; Groenewoud, J.M.M.; Keunen, J.E.E.; Peters, P.J.H.; Dijkman, G.; Souied, E.H.; MacLaren, R.E.; et al. Half-Dose Photodynamic Therapy versus High-Density Subthreshold Micropulse Laser Treatment in Patients with Chronic Central Serous Chorioretinopathy: The PLACE Trial. Ophthalmology 2018, 125, 1547–1555. [Google Scholar] [CrossRef]
- Breukink, M.B.; Downes, S.M.; Querques, G.; van Dijk, E.H.C.; den Hollander, A.I.; Blanco-Garavito, R.; Keunen, J.E.E.; Souied, E.H.; MacLaren, R.E.; Hoyng, C.B.; et al. Comparing half-dose photodynamic therapy with high-density subthreshold micropulse laser treatment in patients with chronic central serous chorioretinopathy (the PLACE trial): Study protocol for a randomized controlled trial. Trials 2015, 16, 419. [Google Scholar] [CrossRef]
- Roca, J.A.; Wu, L.; Fromow-Guerra, J.; Rodríguez, F.J.; Berrocal, M.H.; Rojas, S.; Lima, L.H.; Gallego-Pinazo, R.; Chhablani, J.; Arevalo, J.F.; et al. Yellow (577 nm) micropulse laser versus half-dose verteporfin photodynamic therapy in eyes with chronic central serous chorioretinopathy: Results of the Pan-American Collaborative Retina Study (PACORES) Group. Br. J. Ophthalmol. 2018, 102, 1696–1700. [Google Scholar] [CrossRef]
- Wu, Z.; Wang, H.; An, J. Comparison of the efficacy and safety of subthreshold micropulse laser with photodynamic therapy for the treatment of chronic central serous chorioretinopathy: A meta-analysis. Medicine 2021, 100, e25722. [Google Scholar] [CrossRef] [PubMed]
- Chehade, L.; Chidlow, G.; Wood, J.; Casson, R.J. Short-pulse duration retinal lasers: A review. Clin. Exp. Ophthalmol. 2016, 44, 714–721. [Google Scholar] [CrossRef] [PubMed]
- Filloy, A.; Chong, V.; Solé, E. Subthreshold yellow laser for fovea-involving diabetic macular edema in a series of patients with good vision: Effectiveness and safety of a fovea-sparing technique. BMC Ophthalmol. 2020, 20, 266. [Google Scholar] [CrossRef] [PubMed]
- Gawęcki, M.; Jaszczuk-Maciejewska, A.; Jurska-Jaśko, A.; Kneba, M.; Grzybowski, A. Transfoveal Micropulse Laser Treatment of Central Serous Chorioretinopathy within Six Months of Disease Onset. J. Clin. Med. 2019, 8, 1398. [Google Scholar] [CrossRef] [PubMed]

| Layer | Baseline * | 6 Weeks * | p | 12 Weeks * | p | 24 Weeks * | p |
|---|---|---|---|---|---|---|---|
| CT | 374.9 ± 81.1 | 345.3 ± 71.5 | 0.0566 | 325.8 ± 59.2 | <0.05 | 280 ± 114.6 | <0.05 |
| Haller layer | 312.1 ± 71.3 | 287.4 ± 64.3 | 0.0953 | 274 ± 55.1 | <0.05 | 246 ± 115.9 | <0.05 |
| C-S | 62.8 ± 23.9 | 57.93 ± 20.8 | 0.3164 | 51.8 ± 18.3 | <0.05 | 34 ± 20.8 | <0.05 |
| Baseline * | 6 Weeks * | p | 12 Weeks * | p | 24 Weeks * | p | |
|---|---|---|---|---|---|---|---|
| CT | 293.0 ± 85.2 | 275.3 ± 73.4 | 0.3923 | 273.7 ± 65.0 | 0.9291 | 241.2 ± 113.8 | 0.1731 |
| Haller layer | 250.6 ± 75.4 | 238.4 ± 67.8 | 0.5125 | 236.9 ± 62.4 | 0.4464 | 245.8 ± 61.2 | 0.7876 |
| C-S | 42.4 ± 19.8 | 36.8 ± 12.4 | 0.1944 | 36.7 ± 13.4 | 0.1968 | 34.4 ± 7.4 | 0.0571 |
Disclaimer/Publisher’s Note: The statements, opinions and data contained in all publications are solely those of the individual author(s) and contributor(s) and not of MDPI and/or the editor(s). MDPI and/or the editor(s) disclaim responsibility for any injury to people or property resulting from any ideas, methods, instructions or products referred to in the content. |
© 2023 by the authors. Licensee MDPI, Basel, Switzerland. This article is an open access article distributed under the terms and conditions of the Creative Commons Attribution (CC BY) license (https://creativecommons.org/licenses/by/4.0/).
Share and Cite
Torrellas, B.; Filloy, A.; Wu, L.; Chhablani, J.; Romero-Aroca, P. Effectiveness, Safety and Choroidal Changes of a Fovea-Sparing Technique for the Treatment of Chronic Central Serous Chorioretinopathy with Yellow Subthreshold Laser. J. Clin. Med. 2023, 12, 1127. https://doi.org/10.3390/jcm12031127
Torrellas B, Filloy A, Wu L, Chhablani J, Romero-Aroca P. Effectiveness, Safety and Choroidal Changes of a Fovea-Sparing Technique for the Treatment of Chronic Central Serous Chorioretinopathy with Yellow Subthreshold Laser. Journal of Clinical Medicine. 2023; 12(3):1127. https://doi.org/10.3390/jcm12031127
Chicago/Turabian StyleTorrellas, Beatriz, Alejandro Filloy, Lihteh Wu, Jay Chhablani, and Pedro Romero-Aroca. 2023. "Effectiveness, Safety and Choroidal Changes of a Fovea-Sparing Technique for the Treatment of Chronic Central Serous Chorioretinopathy with Yellow Subthreshold Laser" Journal of Clinical Medicine 12, no. 3: 1127. https://doi.org/10.3390/jcm12031127
APA StyleTorrellas, B., Filloy, A., Wu, L., Chhablani, J., & Romero-Aroca, P. (2023). Effectiveness, Safety and Choroidal Changes of a Fovea-Sparing Technique for the Treatment of Chronic Central Serous Chorioretinopathy with Yellow Subthreshold Laser. Journal of Clinical Medicine, 12(3), 1127. https://doi.org/10.3390/jcm12031127

